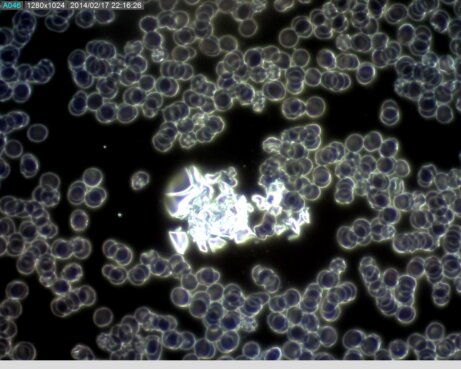

Analýza živé kapky krve
Kapka, která změní váš pohled na zdraví

Představte si, že byste mohli nahlédnout přímo do svého těla a vidět, co se v něm skutečně děje. A díky analýze živé kapky krve to můžete skutečně udělat.
Jediná kapka krve pod speciálním mikroskopem dokáže odhalit, proč se cítíte unavení, proč vás trápí zažívací potíže nebo proč se vám nedaří zhubnout...
Krev je zrcadlem celého těla - odráží vše, co se v těle skutečně děje
Co je analýza živé kapky krve
Analýza živé kapky krve je fascinující metoda, při které pomocí speciálního mikroskopu s temným polem (darkfield) společně pozorujeme vaši čerstvě odebranou kapku krve. Krev nikam neposílám, pozorujeme ji ihned po odebrání, v jejím přirozeném, živém stavu.
Je to jako otevřít okénko přímo do vašeho těla a nahlédnout do jeho tajemství.
V mikroskpu spatříte na vlastní oči vaše krvinky, plazmu a možná objevíte i struktury, které by v krvi být neměly.
Je to jedinečný zážitek, který vám pomůže lépe porozumět vašemu tělu, zdravotním potížím a najít cestu k lepšímu zdraví, přirozené rovnováze a vitalitě.
Vaše krev vypráví příběh, který stojí za přečtení
Proč právě analýza kapky krve
Naše těla denně bojují s moderním životním stylem – stresem, znečištěným prostředím, průmyslově zpracovanými potravinami.... Tyto vlivy se projevují na buněčné úrovni mnohem dříve, než pocítíte první příznaky nemoci.
Běžná vyšetření tyto změny nemusí zachytit nebo je identifikují, až když se projeví jako závažnější zdravotní problém.
Díky analýze kapky krve můžete tyto změny vidět a zasáhnout dříve, než se promění v chronické obtíže.
Analýza vám napoví, v jakém stavu je vnitřní prostředí vašeho těla a vy pochopíte, proč se stále necítíte dobře a máte různé zdravotní problémy.
Co všechno vaše krev prozradí
Tato analýza je jako dobrodružná výprava, na které můžete zjistit:
- stav hydratace a dehydratace těla (naprosto zásadní pro správné fungování)
- stav okysličení organismu a průchodnosti krevních kapilár
- životnost červených krvinek a jejich schopnost vázat kyslík
- stav viskozity krve
- riziko infarktu, mozkové mrtvice
- možný deficit železa, kyseliny listové a B12 (anémie)
- možné chronické a akutní záněty, alergie, snížení imunity
- stav acidobazické nerovnováhy v těle (překyselení), nelze však stanovit přesné pH krve
- stav detoxikace organismu
- těžké kovy v krvi
- potřebu antioxidantů, poškození volnými radikály
- stav oxidativního stresu – chemického, psychického, fyzického i mikrobiálního
- narušení střevní rovnováhy - známky dysbiózy, přemnožené kvasinky a plísně, nedostatečné trávení živin, zvýšenou propustnost střevní stěny
- možné přetížení jater a sleziny
- potřebu jíst více probiotických potravin
- riziko dny - hromadění kyseliny močové, urátové krystaly
- orientační stav zpracování tuků a jednoduchých saharidů ze stravy
- nadměrnou konzumaci živočišných bílkovin, nestrávených bílkoviny, přetížení jater a sleziny
- potíže s krevním cukrem, příliš cukru ve stravě
- případné přetížení některých orgánů a orgánových soustav
Jedna kapka krve odhalí víc než tisíc slov. Konečně můžete najít skutečné příčiny vašich zdravotních potíží a řešit je u kořene.
Co vám analýza kapky krve přinese
Odpovědi na otázky, které vás trápí
- Proč se cítíte stále unavení, i když dostatečně spíte a podle oficiálních testů jste zdraví.
- Proč vás trápí opakované zažívací potíže, které léky zatím jen dočasně tlumí.
- Proč vaše tělo nereaguje na diety a nedaří se vám zhubnout.
- Proč máte problémy s krevním tlakem (vysokým nebo nízkým).
- Proč máte potíže s cévním systémem.
- Proč vaše imunita nedokáže bojovat s běžnými infekcemi.
- Proč se vám vrací kožní problémy a alergie.
Pohled pod povrch vašich potíží
- Uvidíte, jak efektivně vaše krev přenáší kyslík a živiny do tkání
- Můžete odhalit skryté záněty, které mohou stát za mnoha chronickými obtížemi
- Zjistíte, zda vaše tělo bojuje s toxickým zatížením
- Poznáte skutečný stav vašeho imunitního systému
- Zjistíte, jaké je vaše vnitřní prostředí, zda vaše tělo nejeví známky překyselení
Individuální plán obnovy vašeho zdraví
- Dostanete konkrétní protokol přírodních a bylinných preparátů
- Specifické kroky k detoxikaci a posílení vašeho organismu
- Konkrétní doporučení pro váš životní styl
- Praktické tipy, jak podpořit přirozenou schopnost těla se uzdravit, jak začít tělo vnímat jinak
Motivaci a pochopení
- Uvidíte na vlastní oči souvislosti mezi tím co jíte, jak žijete a stavem vaší krve a vašeho zdraví
- Získáte hluboké pochopení, jak vaše tělo funguje a co potřebuje
- Objevíte cestu k trvalému zlepšení zdraví, ne jen k potlačení příznaků
Když se poprvé podíváte do mikroskopu na svoji krev, je to jako když se díváte přímo do nitra svého těla.
Nejčastější nálezy v kapce krve

Takto vypadá v darkfield mikroskopu zdravá krev. Upřímně řečeno, ještě jsem se s takovou krví nesetkala. Je to ideál, ke kterému se snažíme co nejvíce přiblížit pomocí správné výživy, hydratace a detoxikace. I malý posun směrem k tomuto stavu přináší výrazné zlepšení zdraví a vitality.

Překyselení těla, dehydratace. To jsou hlavní známky, když jsou červené krvinky pospojované do ruloforem (řetízků). V takovém případě je tělo nedostateně okysličováno a zásobováno živinami. Cílenou detoxikací, dodáním potřebných minerálů, vitamínů a správným pitným režimem se snažíme tento stav změnit. Lidé s tímto nálezem bývají hodně unavení. V dnešní době tento stav vidím téměř u každého člověka.

Agregace červených krvinek představuje velké riziko. Ukazuje na toxickou zátěž, překyselení, zvýšenou viskozitu krve. Je potřeba tělo alkalizovat, hydratovat, dodat antioxidanty a další nezbytné látky.

Těžké kovy v krvi mohou připomínat hvězdnou oblohu, ale představují obrovskou toxickou zátěž. Je potřeba zvolit vhodný detoxikační program a přírodní produkty, které je dokáží navázat a odvést z těla ven. Lidé s takovouto toxickou zátěží si stěžují na ekzémy, alergie, bolesti hlavy, velkou únavu a další potíže.

Metabolický odpad ukazuje na špatnou stravu a problémy s trávením. Na snímku je vidět společně se zátěží těžkými kovy.
Urátové krystaly vypadají v krvi krásně, ale jsou známkou překyselení těla a nebezpečí dny. Dna vzniká při vysoké hladině kyseliny močové v krvi, která se ve formě těchto krystalků ukládá v kloubech, zejména v kloubech na palcích u nohy, ale může být ukládána i do jiných kloubů. Dna oslabuje také ledviny. Je potřeba cílená detoxikace a úprava stravy.
Toto je jen několik ukázek, co všechno lze v jediné kapce krve objevit. Zátěže jsou obrovské a je potřeba si uvědomit, že se v krvi nevyskytuje pouze jedna z nich, ale vždy jde o kombinaci několika různých zátěží.
Analýzou to nekončí
Když zjistíte, jak vypadá vaše krev a vnitřní prostředí vašeho těla a pochopíte souvislosti s vašimi obtížemi, společně navrhneme řešení přímo pro vás.
Nejprve se podíváme na váš pitný režim, stravování a životní styl.
Poté sestavíme program přesně pro vaše potřeby, ať už potřebujete detoxikaci, snížení zánětu v těle nebo podporu metabolismu a zhubnutí. Váš program bude zaměřen na úpravu pH těla, posílení imunity a obnovení přirozené rovnováhy.
Doplníme také chybějící minerály, vitamíny, antioxidanty a další látky... Zkrátka dosytíme tělo, aby mohlo opět správně fungovat.

Kapka krve, moře překvapení: První reakce klientů
Vyšetření kapky mě překvapilo. Překvapilo mě, jak krásnou krev máme, co všechno je v mikroskopu vidět a jak to souvisí s naším zdravím a pocitem komfortu. Když to vidím na vlastní oči, má to úplně jinou váhu a rázem mám větší pochopení, jak je důležité se o sebe starat. Pomohlo mi to v ujasnění spojitostí a v rozhodnutí se do očisty pustit. Děkuji moc za takové pošťouchnutí. 🤗😉
Přišla jsem naprosto vyčerpaná, i po osmi hodinách spánku jsem se cítila jako přejetá vlakem. Lékaři nenašli nic konkrétního, prý je to stresem. Analýza kapky krve odhalila slepené červené krvinky, těžké kovy a známky chronického zánětu. 😳 Po třech měsících cílené metabolické kúry jsem znovu našla svou energii. Nejlepší byl ten moment, kdy jsem si uvědomila, že únava není normální stav, který musím přijmout. Konečně zase žiju, místo abych jen přežívala. 🙂
Seznámila jsem se se zajímavou metodou - analýzou kapky krve. Velice mě překvapilo, co všechno se dá z jediné kapky zjistit. Všechno, co jsem viděla mi bylo srozumitelně vysvětleno. Díky této metodě jsem pochopila moje problémy s dušnosti a zadýcháváním se. A také, že je lze řešit. Tuto metodu doporučuji každému, kdo se zajímá o své zdraví. Nikdy není pozdě začít o sebe více pečovat.
S analýzou kapky krve jsem se setkala poprvé a velmi mě překvapila spojitost mezi zdravotními potížemi a nalezenými anomáliemi. Už se těším na výsledky doporučené detoxikační kúry😊…
Pro koho je analýza vhodná
Tato metoda je ideální pro vás, pokud:
- se cítíte unavení, bez energie, máte problémy se spánkem
- trpíte chronickými zdravotními potížemi
- chcete zlepšit svou imunitu a odolnost vůči infekcím
- hledáte skutečné příčiny svých zdravotních obtíží, ne jen potlačení symptomů
- hledáte přírodní cestu k obnově rovnováhy v těle
- toužíte po konkrétních, individuálních doporučeních
- zajímáte se o holistický přístup ke zdraví
- sázíte na prevenci a raději investujete do svého zdraví dnes, než do léčby zítra
- chcete převzít aktivní roli v péči o své zdraví
Nahlédněte do tajů své krve

Objednejte se na analýzu živé kapky krve
- Nejdříve společně pod mikroskopem prozkoumáme vaši kapku krve. Vše uvidíte na monitoru počítače a také můžete kdykoliv nahlédnout přímo do mikroskopu. Krev
- Průběžně budu pořizovat obrazovou dokumentaci všeho, co ve vaší krvi objevíme. Pokud budete mít zájem, tyto fotky vám následně zašlu na email. Veškeré nálezy vám podrobně vysvětlím přímo během konzultace.
- Potom si s vámi budu ještě chvíli povídat. Budu se vás ptát na vaše zdravotní potíže, jak se stravujete, jaké užíváte doplňky stravy, jaký máte pitný režim, abych pochopila souvislosti.
- Nakonec vám navrhnu individuální detoxikační program, dávkování a způsob užívání. Případně probereme jaké změny v životním stylu a stravě by pro vás byly nejvhodnější.
- Pro sledování vašeho pokroku je ideální po 2-3 měsících provést kontrolní analýzu, která jasně ukáže pozitivní změny ve vaší krvi.
Délka konzultace: 60 - 90 minut
Cena: 1 700 Kč
Kapacita: Vzhledem k důkladnosti analýzy a individuálnímu přístupu ke každému klientovi přijímám pouze 8 klientů týdně.
Analýzu pravidelně provádím v těchto lokalitách:
- Vrchlabí
- Čelákovice
Pro majitele wellness center, fitness studií, kosmetických a kadeřnických salonů nebo center celostní medicíny: Po domluvě přijedu s mikroskopem přímo k vám a provedu analýzu pro vaše klienty. Pro více informací o této spolupráci mě kontaktujte zde: